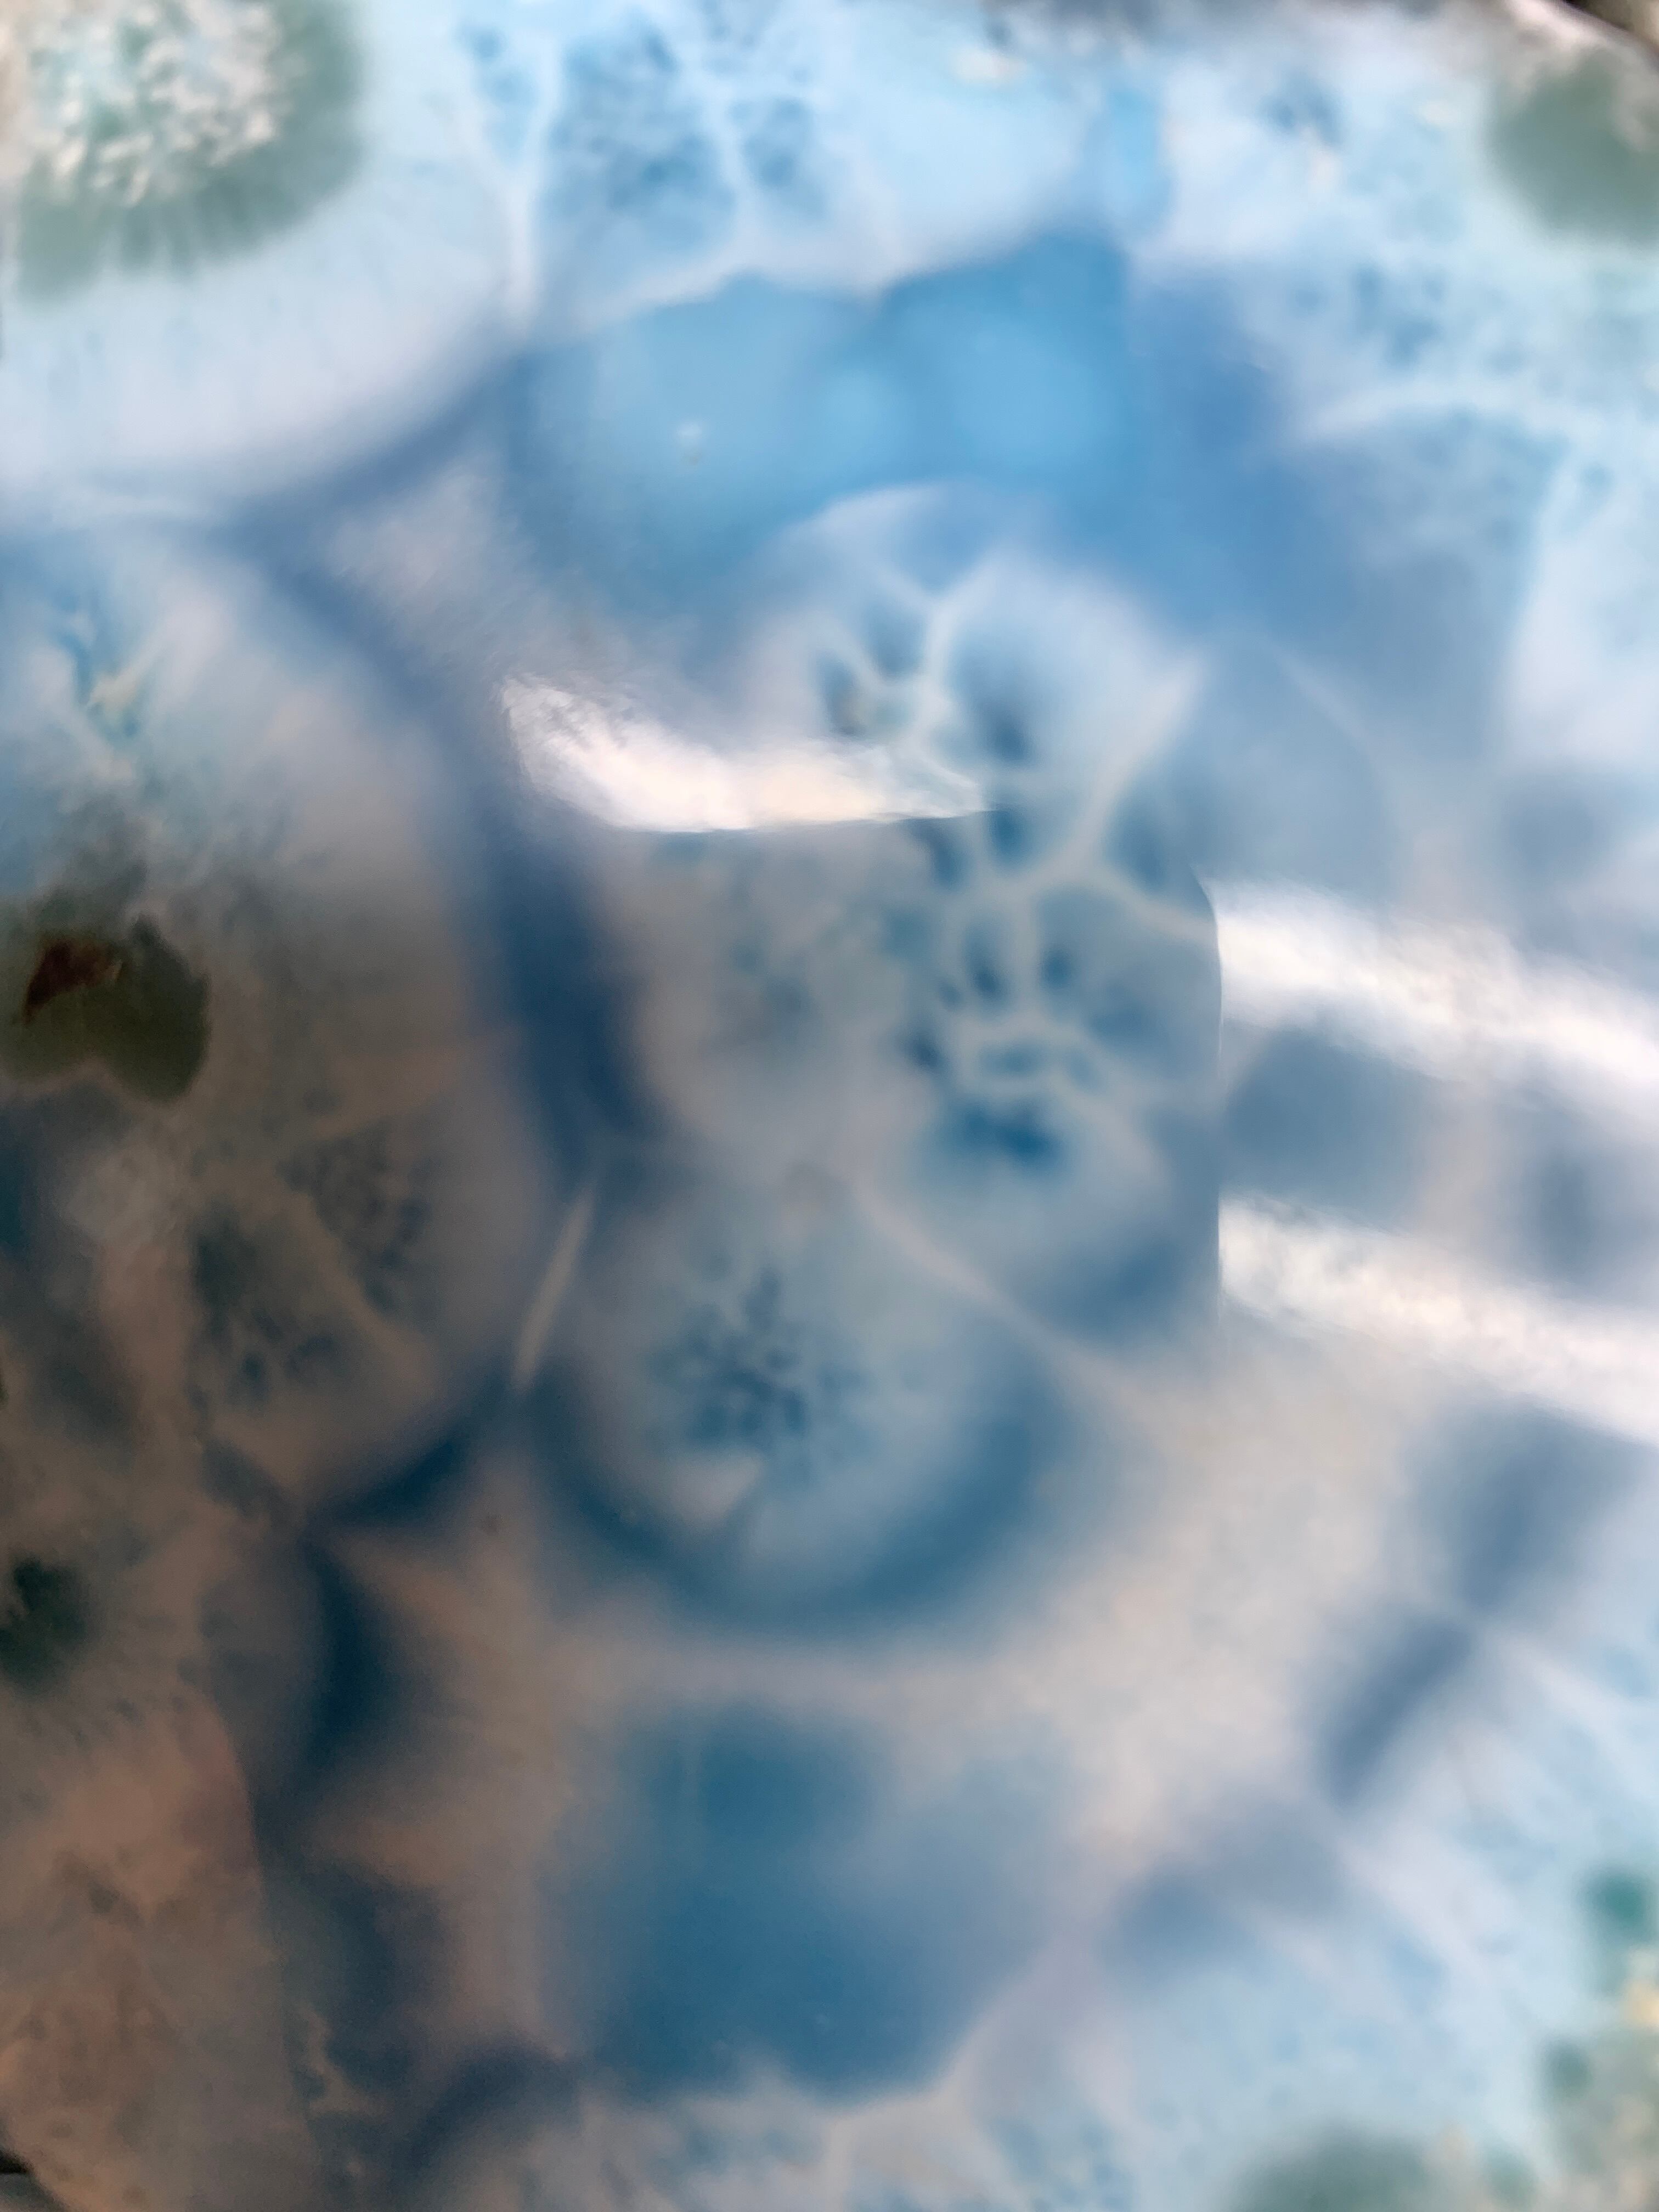

販売開始が近くなりましたら、登録したメールアドレス宛にお知らせします。
- ※ 販売の期間変更や、販売停止時にはメールは送信されません。
- ※ @thebase.inからのメール受信許可設定をお願いします。
メールアドレス
折返しのメールが受信できるように、ドメイン指定受信で「thebase.in」と「gmail.com」を許可するように設定してください。
アプリで、お気に入りすると
販売開始をすぐにお知らせ
アプリを開く
販売開始のお知らせを受け付けました
ご記入いただいたメールアドレス宛に確認メールをお送りしておりますので、ご確認ください。
メールが届いていない場合は、迷惑メールフォルダをご確認ください。
通知受信時に、メールサーバー容量がオーバーしているなどの理由で受信できない場合がございます。ご確認ください。
折返しのメールが受信できるように、ドメイン指定受信で「thebase.in」と「gmail.com」を許可するように設定してください。